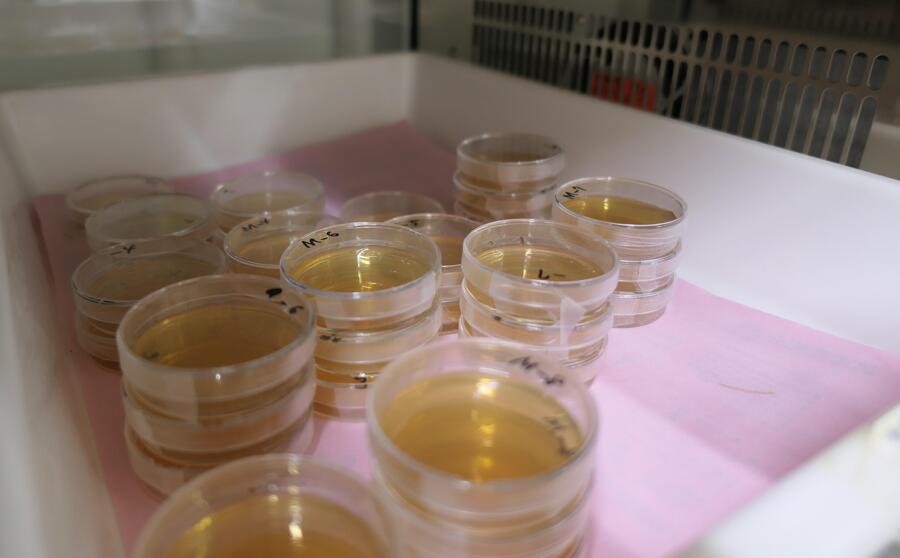

SAGANO BLOG
- >
- SAGANO BLOG
- >
- 日々の様子
2024年04月09日
2024年4月8日、今日はそれぞれのはじまりの日でした。
【始業式】
はじめて嵯峨野高校に来られた先生方...生徒のみなさんの心に、どんな好奇心の波紋を広げてくださるのか、とても楽しみです。
生徒部長の原田先生からは...新たな規定についてご説明と「実りある学校生活について」改めて考えるきっかけとなるお話をいただきました。
そして吉村校長先生...
生徒のみなさんの目を見ながら、じっくり語りかけるように以下2点についてお話しされました。
「できたこと」もしっかり評価して、充実した1年に
3学期修了式でPDCAサイクル(Plan/Do/Check/Action)という方法についてお話ししたが、みなさんには、反省ばかりでなく「できたこと」をしっかり評価してほしい。PDCAサイクルだけでなく、人それぞれに自分に合う方法を見つけることも大切。行動を先行するDCAPサイクル、ほかにもOODAループ(Observe/Orient/Decide/Act)やSTPDサイクル(See/Think/Plan/do)など充実した1年を過ごすために計画を立てる方法は様々にあります。一度に無理な計画を立てず、1年という長期目標を元に、1週間くらいの短いサイクルで何度もこれらを回し、さらに改善を図ることを心掛けてください。
長続きする「幸福」とは?
2021年「ウェルビーイング」学会が設立され、近年話題になっています。代表理事で慶應義塾大学大学院の前野隆司教授によると「ウェルビーイング」とはWell=良い、Being=状態。つまり「心と体と社会が良い状態」のこと。しかし、何を「良い状態」と感じるか個人差は大きい。そこで前野教授は「長続きしない幸福の条件」を明らかにし、さらに「長続きする幸福の因子」を整理されました。ぜひ、この幸福の因子を意識しながら、自分を見つめ直してみましょう。ここにいる全員がウェルビーイングを実感できる1年となることを願っています。
・長続きしない幸福の条件
社会的地位・お金・モノなど、他人と比較することで得られる幸せは長続きしない
・長続きする幸福の因子*人が幸せを感じる4つの因子
「やってみよう」因子(自己実現と成長)
「ありがとう」因子(つながりと感謝)
「なんとかなる」因子(前向きと楽観)
「ありのままに」因子(独立と自分らしさ)
...そして午後からは、見事な彩を添えてくれた桜に囲まれて、
京都府立嵯峨野高等学校第76回入学式が挙行されました!
【校長式辞】
「和敬(和をもって敬うこと)」「自彊(自ら務めて励むこと)」「飛翔(新しい世界に飛び立つこと)」本校の教育活動はすべてこの校是のもとに行われています。みなさんもこの3つの校是を心に刻み、日々その実践を心掛けてください。また自分が進むべき方向を正しく見極めるためには、世の中全体を幅広く見渡し、様々な意見や考え方に触れ、物事を色々な角度から捉える力が重要になってきます。それが「俯瞰」する力です。
本校で力を入れている探究(ラボ)活動でも、この力が必要です。実験方法やデータにばかり目を奪われ「俯瞰」する視点を忘れた探究は、目的そのものを見失ってしまうことにもなりかねません。
また、この「俯瞰」する力は人との関係をうまく築くうえでも欠かせません。相手のことを狭い視野で一面的に見ていたのでは、相手の良さに気付くことができなかったり、相手のことを客観的に理解できなかったりするでしょう。
さらに、自分自身を「俯瞰」する力も大切です。自分自身を少し離れたところから見ると、自分の足りない部分や考えの間違い、もしくは自分の良さや魅力が見つかることもあります。そして何かに悩んで出口が見えなくなった時でも、自分を「俯瞰」することで冷静さを取り戻し、光が見えてくることがあります。
こうした力は「メタ認知能力」などとも呼ばれ、様々な分野で重要視されています。みなさんの周りにはまだまだ知らない世界が広がっています。「俯瞰」する力をぜひ心掛けてください。三年後、みなさんが今は想像もつかないような、大きく成長した自分と出会えることを心から願っています。
この言葉を受けて生徒の宣誓と決意表明が続きました。
新しい制服のせいでしょうか...すでに中学生とは異なる顔つきになっています。
そして新入生担任の先生方の登壇...
校長先生は式辞のなかで保護者等のみなさまに向けて「新しい家族を迎えたという気持ちで教育に力を注ぐ」と宣言されました。もちろん教職員一同、おなじ気持ちです。...そして新入生が「新しい家族」ならば...「お兄ちゃん」「お姉ちゃん」も、なぜかすでに同じ気持ちのようです。先週、ワンダーフォーゲル部をはじめ、先輩たちが1年生が使う下駄箱等の大掃除をしていました。...しかも、なんだか嬉しそう。
そして新入生のみなさんがはじめて歌う校歌は、吹奏楽部の先輩方が生演奏で支えてくれました!
つまり...
「新入生のみなさん、みんなで待ってましたよ!ようこそ、嵯峨野高校へ!!」ということです。
さぁ、私たちの高校生活のはじまりです!!
2024年04月01日
嵯峨野高校のしだれ桜は少しピンク色が濃く、艶やかな色です。デザイン工芸部では、この桜の美しさに負けぬ「ゆかた」作るべく、いまだ無地の反物と部長が格闘しております。
春休み中には、なんとか下図を反物に写すところまで進むつもりです。・・・が、その柄の場所が難しいのです。御協力いただいている「和衣庵」さまにお尋ねすると、着物には華やかな柄を入れる、おおよその場所が決まっているそうです。
着衣した状態で、右肩から胸・左袖の外面と左肩から背中・右袖の内面が大事だそうで、振り袖や格式のある着物はだいたいこの型になっているとのこと。ここに柄があると、日本文化の所作をするとき、美しく見えるそうです。「三味線を弾くポーズをして見える場所」と覚えるとよいとのこと。
・・・たしかに、日本美人の代表「見返り美人図」は左肩から背中を手前に見せて振り返っていますね。さすが菱川師宣先生。
色々と教えていただき、楽しく日本文化を学びながらゆかたの制作に励む部長なのでした。
2024年04月01日
いよいよ桜が咲きました!!
春の陽射しを待ちわびていたのは、生徒の皆さんも同じようです。
嵯峨野高校では、テニス部の日焼けの度合いでも季節の移ろいがわかります。
普段は優しくおっとりとした生徒の顔が、部活ではキリッと変わります。
この集中力、頼もしい限りです。
格技場では卓球部と剣道部が活動していました。
張り詰めた緊張感。どちらも一瞬を競う競技ですね。
中庭では桜の開花に急かされるように、ダンス同好会が熱心に活動しています。


大会でもあるのかな?話を聞いてみると...
「新入生歓迎会のために練習しています」とのこと。
どうやら生徒のみなさんは、桜ではなく新入生を待っているようす。
新学期に向けて、先輩としての準備があるのですね。
4月1日、生徒の成長とともに、春の陽射しが眩しく見える本年度の始まりでした。

2024年03月29日
3月24日に鯖江市で行われた第3回CyberSakura決勝ラウンドにおいて、嵯峨野高校コンピュータ部から参加したチーム「HEXAGON」が見事優勝しました。
CyberSakuraは2021年に始まったサイバーセキュリティ分野の人材育成を目的とした教育プログラムで、鯖江市・総務省・デジタル庁・警察庁・福井県警察・防衛省の後援を受けています。参加できるのは日本国内の中学生・高校生・高専生(1〜3年)で、3~4人のチームを作って参加します。競技内容は、仮想のコンピューター上で脆弱な設定や状況を改善することで獲得できるスコアをチーム対抗で競うというものです。

会場に到着しました

競技中の様子
決勝ラウンドではWindows Serverの課題が追加された上に、Windows・Ubuntuの難易度が予選ラウンドよりも更に高くなっていました。
応援ありがとうございました!
2024年03月27日
3学期の情報Ⅰの授業では、「SDGs」をテーマにグループで探究学習に取り組みました。
まず生徒たちは自分の興味・関心について考え、それをもとにグループに分かれ、グループで1つの問いをつくりました。その後、文献調査等を進め、根拠となる事例や専門家の意見などを集めて問いに対する結論を出しました。そして、探究した内容をスライドにまとめ、グループごとに発表を行いました。
2年生ではさらに高度な探究学習に取り組むので、今回の活動がよい経験になったと思います。
以下ではクラス内での発表の様子をお届けします。スライドや話し方、発表姿勢など様々な面で工夫が見られました。
































2024年03月22日
3月19日に行われました第65回日本植物生理学会高校生生物研究発表会にスーパーサイエンスラボ生物ラボから18人が参加しました。全国から70テーマのポスター発表が行われ、熱気あふれる会場の中、大学の研究者、大学生、他校の先生や生徒から鋭い質問が飛び交いました。
発表の際には、聴講いただいた方に合わせて柔軟に対応できたと思います。中には研究した生物が専門の先生が見てくださり、活発な助言(生物愛談義?)も繰り広げられます。
「カイワレ大根にストレスを与えた場合のポリフェノール量の変化」を発表したチームが顧問審査員賞を受賞しました!二人には今学会の感想を書いてもらいました。
学会:第65回日本植物生理学会
参加者:藤井麗子、湯川瑞結
私たちは、第65回日本植物生理学会年会特別企画 高校生生物研究発表会に参加しました。全国各地から34校が参加し、ポスター発表や各学校のSSHの取り組みの紹介などが行われました。今回の研究発表会では、大学生や他校の先生など、たくさんの方にさまざまな観点からの意見を聞くことができ、私たちにとってとても貴重な経験となったと思います。発表後には自分たちのテーマや実験について多くの改善点や新しい実験の活用の仕方を学ぶことができました。自分たちの研究を評価していただけたことがとても嬉しかったです。この経験を通して探究活動の面白さを改めて感じられたと思います。

自らの研究を発表できたことは勿論、他校のレベルの高い研究を見て、様々な意見をもらうことで成長できた1日でした。
2024年03月22日
 スーパーサイエンスラボ、アカデミックラボの生徒各5名ずつが、「第6回 高校生サイエンス研究発表会2024」(主催 第一薬科大学・日本薬科大学・横浜薬科大学)において研究発表を行いました。今回はZOOMによるオンライン発表形式で、3月12日と13日に、それぞれ以下の2件の発表を行いました。
スーパーサイエンスラボ、アカデミックラボの生徒各5名ずつが、「第6回 高校生サイエンス研究発表会2024」(主催 第一薬科大学・日本薬科大学・横浜薬科大学)において研究発表を行いました。今回はZOOMによるオンライン発表形式で、3月12日と13日に、それぞれ以下の2件の発表を行いました。
「段差がドミノの倒れる速度に与える影響について」
「自然由来の化粧品原料を探し求めて~京野菜とキンモクセイの秘める効能~」
生徒は少し緊張しながらも、発表及び質疑応答をしっかりと行いました。
2024年03月21日
令和6年2月18日 京都府高等学校理科教育研究会連絡協議会主催の令和5年度高校生理科研究発表会が、京都市青少年科学センターにて行われました。
7校から16本の研究発表がありました。部活動や課題研究で行った研究などをプレゼンテーションし、活発に交流が行われました。
本校のSSHの取組であるスーパーサイエンスラボの地学(気象)ラボから「 逃げ水発生時の気象観測」のタイトルで発表しました。夏場の道路で見られる逃げ水と、そのときの気温分布を観測し、発生要因やメカニズムを解き明かしたいと思って研究してきました。

緊張もありましたが、自分たちの言葉で伝えることができました。この経験を活かして、今後も研究を続けていきます。
2024年03月19日
本日、体育館にて修了式が行われました。
約1年ぶりに全校生徒が体育館に集まり、校歌斉唱から始まりました。
校長先生の式辞では
PDCAサイクルへの言及から始まりました。PDCAサイクルとはPlan(計画)、Do(実行)、Check(測定・評価)、Action(対策・改善)の仮説・検証型プロセスを循環させ、マネジメントの品質を高めようという概念です。このサイクルで重要なのは、CheckとActionの部分である。春休みのうちに、この1年、自分ができたことはなにかをしっかり意識して振り返り、4月からの新しい計画に繋げて欲しい。
さらに、阪神タイガースの矢野前監督の言葉を紹介しながら、自分が成功できると信じ切ることの大切さなどに触れ、4月から新しい目標に向けて頑張ってほしいとの言葉がありました。
生徒指導部長からは
制服の「正装」変更について経緯を添え説明がありました。そして、教育目標(安全安心・全員が主人公・感謝)について振り返りがありました。在校生の自己肯定感や自己有用感を高めたいという想いから設定に至ったという経緯のお話がありました。
進路指導部長からは
この春受験を頑張った3年生に想いを馳せ、彼らの受験勉強の体験を記した「合格体験記」を紹介しました。そのうち、夢をあきらめず、苦手を克服して志望校に合格した一人について焦点を当て、来年度学年が上がる在校生へ、自分が何をしたいか。どんな世界になって欲しいかを考えること。挑戦者になること。周りの人の力を借りること。それらを踏まえ頑張って欲しいとのお話がありました。
その後、伝達表彰式を行いました。
2024年03月15日
前回(2/20)に引き続き、ご紹介します。
この透明な筒はなんですか?
「セル」だそう。この中に液体を入れて、「吸光度」と言うものを測定するらしいです。
難しい機器を使いこなしていました。すごい。
臭いが・・・。何をしているのですか。
食品にカビを生やし、そこから「ペニシリン」を抽出しているとのこと。あの有名な漫画&ドラマに影響を受け、自分たちにも抽出できるか試してみたいと思い研究を始めたそうです。
その後、抽出したペニシリンで納豆菌を抗菌することができたそう!すごい。リアルJIN!
中央の黒い物がカビの塊でその周りのクリーム色の物が納豆菌です。
何度も試行錯誤したそうで、うまくいった時はとっても嬉しそうでした。
憧れや感動は、人を動かすのですね。
このすごい形の植物はなんですか。
「ハエトリソウ」という食虫植物です。ぎざぎざの葉の中に迷い込んだ虫を挟んで捕食し、栄養を取る植物だそう。そんな珍しい生活スタイルを持った植物に興味をもったそうで、消化時間について調べているそうです。
植物の世話も自分たちで行い、花も咲かせたそうです。
こちらは、何やら、データ処理中。
「苔」が環境汚染の指標にならないか検証しているそうです。京都市内の数地点に生えている苔の種類とその生育環境を調べているそう。苔って皆同じに見えますが、きちんと図鑑を使って種類を特定し、地域ごとの分布を調査していました。地道な努力。尊敬します!
こちらは、コンピュータールーム。ここにも生物ラボの生徒が、学会に参加するそうで、発表ポスターを作り始めたとのこと。データの整理など、相談しながら行っていました。
生物ラボでは、様々な生物を扱い、自分の興味関心をもとに日々研究に取り組んでいます。
2024年03月06日
嵯峨野高校には伝統文化を学べる施設があります。粘土の成形から焼成まで全て学内で体験できる陶芸室では、今年度、茶道部がお点前で使う茶碗を作成しました。
そして、藍染やさまざまな染め物体験ができる染色室では、これからデザイン工芸部がゆかた制作に挑みます。
先日、地元京都の企業「和衣庵」さまのご協力を得て、柄合わせの位置の手掛かりとなる「墨打ち」や和裁の裁断方法など、ゆかた制作の一連の流れを教えていただきました。
とても親身になって相談にのってくださり、生徒が考えた図案をもとに完成まで引き続きご協力・ご指導いただきます。
嵯峨野高生がゼロから挑む、はじめてのゆかた作り。今はまだ、おっかなびっくり状態です...どうなることやら。
(言われるがままに採寸されている部長)↓
今後、時折り制作過程を更新いたします。
どうぞみなさま温かい目で応援よろしくお願いいたします。
2024年03月05日
 令和6年3月1日金曜日
令和6年3月1日金曜日
眩い光のなか、多くの人に祝福されて3年生が巣立っていきました。
これまでの努力を自信に変えて、羽ばたく姿の何と頼もしいことか。

ずっと前を歩いているので見えなかったけれど、
晴れやかな嬉しさと、別れの辛さを噛みしめて、
最後の引率をする、担任の先生の表情は複雑です。
後ろをついて歩くだけではわからない、
大人のこんな顔も最後に覚えておいてね。
愛されるとはそういうものです。
さあ飛翔のとき。嵯峨野生よ、挑戦者であれ。
2024年03月05日
京都府立高等学校PTA連合会主催の「バイク4ない運動プラス1」啓発ポスターコンクールにおいて、美術部1年生が最優秀賞を受賞いたしました。
本作品は市内の京都府立高校に掲示されます。
ご本人より一言
「まさか自分が選ばれるとは思っていなかったので、驚きと光栄の念でいっぱいです」
生徒の皆さんは可能性の塊です!!
これからも嵯峨野高校はみなさんの「挑戦」を応援します。
おめでとうございます。
2024年02月20日
試験管がたくさん!これはなんですか?
「ミドリムシ」の培養をしているそうです。全部同じに見えますが、それぞれ違う条件だそう。培養大変そうです。
こちらは、顕微鏡でミドリムシがちゃんと培養できているか確認中。顕微鏡を使いこなしていました。
これが、顕微鏡で見ているもの!大きさは40μmぐらい。元気に動いています!
これは、何でしょう。「地衣類」という生物から物質を抽出し、さらに成分ごとに分離しているらしいです。液体がカラフルできれい。
こちらは、何やら長さを測っていました。
「カタバミ」に含まれる成分が生物の成長にどのような影響を与えるのか調べているそう。
調べ方にも色々な方法があるのですね。家の周りにたくさん生えていて、興味をもったみたいですよ。
これはわかめですか?
いいえ、これは「イシクラゲ」と言って教科書にも載っている原核生物。有名な生物なのですね。
ちなみにこちらが顕微鏡で見た様子。細胞が数珠のように連なっています。
学校の敷地内にいるそうで、採取して洗っていました。生物の採取からしているなんて、楽しそうで良いですね!
こちらは、顕微鏡をのぞきながら何やら真剣な様子。何をしているのでしょうか。
「クマムシ」を採取して、乾眠させているらしいです。大きさは0.1mm!なんて小さいのでしょう。肉眼では作業できないので、顕微鏡必須とのこと。慣れた手つきでぽんぽん採取。
それがこちら・・・。研究とは、楽しいからこそ続けられるものなのですね。
こちらがクマムシ乾眠の様子
次回へ続く。
2024年02月06日
2月2日(金)に第2学年で嵯峨野マッチを実施しました。
5種目の競技(ドッジボール、フットサル、ソフトバレー、ボードゲーム、百人一首)をクラス対抗で争い、どの競技も生徒達は楽しみながら真剣に活動していました。
結果は以下の通りです。
総合優勝:6組 準優勝:5組 第3位:2組、4組
嵯峨野マッチ運営委員が事前の準備から当日の運営まで担当し、みんなで協力して作り上げてくれました。配信による委員長の結果発表時には歓声が沸き起こり、盛況のうちに無事終えることができました。
2024年02月05日
京・平安文化論ラボとジュヴァンセル様とのコラボ企画であるチョコレートが、旧三井家下鴨別邸様の喫茶で、提供されることになりました。
会場:旧三井家下鴨別邸 京都市左京区下鴨宮河町58番地2 075-366-4321
京阪電車「出町柳」駅 徒歩5分
期間:令和6年2月10日(土)~2月29日(木)※水曜日は休館日です
開館時間:9:00~17:00(喫茶営業ラストオーダー 16:00)
旧三井家下鴨別邸様は、「文化と観光の融合による文化財の保存と活用の好循環の実現」を運営目的に掲げておられ、施設を一般公開されている他、伝統文化等を身近に体感できるイベントを開催しておられます。
この度、『源氏物語』をテーマにして商品化されたチョコレート3種(「萩の上露」・「絶えぬ思ひ」・「淡月」)を、旧三井家下鴨別邸様の喫茶メニューとして、期間限定で提供されることが決定しました。
私たちの洋菓子のデザイン画も展示されます。
旧三井家下鴨別邸様は、『源氏物語』にも登場する糺の森の中にあります。
この機会に旧三井家下鴨別邸様で、『源氏物語』の世界にひたってみてください。
2024年02月05日
各班思い思いの場所を巡って無事ゴールの京都駅に到着しました。普段当たり前のように生活している場所ですが、このような体験を通して新たな視点で「観光都市としての京都」を観察する機会となったようです。また、普段余り接点がない班の人と色々話す機会がもててとてもよい交流ができたという感想を寄せてくれた生徒が多数見られました。1年生にとっては充実感あふれる、思い出に残る行事の一つとなったようでした。
2024年02月02日
1年生は3時間目からフィールドワークを実施します。事前に各グループで立てた計画書に従って名所史跡などを探索し、指定された時間内にゴールの京都駅を目指します。写真は昇降口付近での出発風景です。行ってらっしゃい!
2024年02月01日
授業も残すところわずかとなってきました。
最後まで研究を頑張っています。
実験器具がたくさん。何の実験をしているのでしょう。
植物に含まれる「ポリフェノール」の量を調べているみたい。難しそう。
植物は、貝割れ大根を発芽させて、それを使っているみたいです。大変そうだけど、楽しそうで良いですね。
こちらは、また違った実験の様子。
見慣れないものがたくさん。これは、「クリーンベンチ」といって、無菌状態で作業するための機器。作業が複雑で難しそうですね。「アクネ菌」を「乳酸菌」で抗菌できるか確かめているそう。自分の悩みから研究を始めたそうですよ。
そして、こちらは、それを培養している様子。結果が出るまでに、1,2日はかかるそう。この中に生物が居るなんて・・。
翌日観察に来ていましたよ。
こちらは、何をしているのでしょう。
「魚」のストレスを調べているそうです。魚にもストレスがあると思って調べたいと思う気持ち、素敵ですね。
縞模様が特徴的なゼブラフィッシュとその飼育水槽
生物ラボでは、授業外の活動が多くなるため生物室で作業した際には、こうやって履歴を自分たちでつけています。
皆さん、研究とお世話の両方、頑張っているんですね!
こちらは、少し狭い部屋ですが、皆さんそれぞれ作業していますね。
次回へ続く。
2024年01月26日
1月24日(水)に、古典の日文化基金未来賞を受賞したことを報告するため、京都府教育委員会を訪問しました。
京都府教育委員会の前川教育長から、お祝いの言葉をいただきました。
そして、ラボでの取り組みについては、「できたことや良かったことだけでなく、これからの課題についても、きちんと分析できていることが良いですね。これからも頑張ってください。おめでとうございます。」と温かい励ましの言葉をいただきました。
また、京洋菓子司ジュヴァンセル様とのコラボ企画で、2月1日から一般販売される洋菓子について、「洋菓子から源氏物語の世界を知るというのは、面白い取り組みです。」とお褒めの言葉をいただきました。
アカデミックラボという探究活動の授業で自分たちが考えたことが一つ一つ形になっていくこと、そして古典の魅力を多くの方に伝えて楽しんでいただけることに、生徒たちはやりがいや充実感を感じています。
さらに、昨年9月に古典の日文化基金未来賞をいただいたことは、この上ない喜びです。
表敬訪問でいただいた言葉を励みに、これからも古典の魅力を発信していけるよう取り組んでいきます。
なお、洋菓子の一般販売は、2月1日(木)から、京洋菓子司ジュヴァンセル様の御池店とオンラインショップで販売されます。(ジュヴァンセル御池店 京都市中京区御池通高倉西入高宮町216 Tel.075-231-7571)
Copyright (C) 京都府立嵯峨野高等学校 All Rights Reserved.